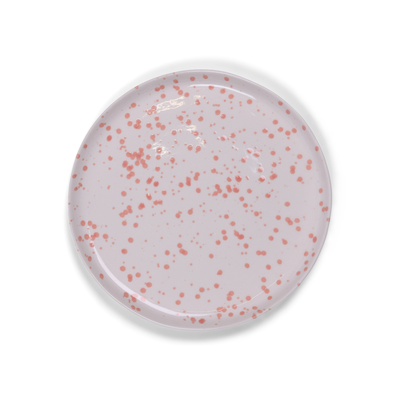
Bord Lucie 15 cm

Loods 5
De eigen collectie van Loods 5 staat garant voor prachtige basics in neutrale kleuren met een eigentijds karakter. Mooie artikelen die goed gemaakt zijn met aandacht voor kwaliteit, zodat je er jaren van geniet. Het assortiment van Loods 5 vindt makkelijk een plekje in je huis, want je gebruikt deze meubels en woonaccessoires iedere dag!